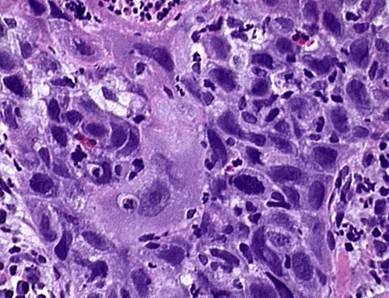

各地 |
北京 | 天津 | 上海 | 重庆 | 河北 | 山西 | 贵州 | 黑龙江 | 辽宁 | 吉林 | 江苏 | 浙江 | 安徽 | 福建 | 江西 | 山东 |
| 河南 | 湖南 | 湖北 | 广东 | 海南 | 四川 | 云南 | 内蒙古 | 广西 | 陕西 | 甘肃 | 宁夏 | 青海 | 西藏 | 新疆 | 全国 |
2012年临床执业助理医师病理学考试辅导讲义 第四章(2)
二、肿瘤的生物学行为——★本单元重点4-1!
关键:注意三个术语的关系:“异型性、分化程度、恶性程度”
(一)肿瘤的异型性
肿瘤组织在结构和细胞形态上,与其起源组织有不同程度的差异,这种形态结构上的差异称为异型性。
恶性肿瘤一般都有明显的异型性。
异型性是区别良、恶性肿瘤的组织学依据。包括两个层次:
1.肿瘤组织结构的异型性
低倍镜下:表现为瘤细胞的排列紊乱和失去正常的层次和结构。

2.肿瘤细胞的异型性
高倍镜下:表现为瘤细胞和细胞核的多形性。
●瘤细胞大小不一,形状不规则,甚至出现奇异瘤巨细胞。
●细胞核增大(核浆比例增大),大小和形状不一,www.wang1.com.cn出现巨核,多核或奇异核,核染色深,染色质呈粗颗粒状且分布不均,核膜增厚核仁肥大,核分裂象多见,并可见不对称或多极等病理性核分裂象。
●胞浆多偏嗜碱性。